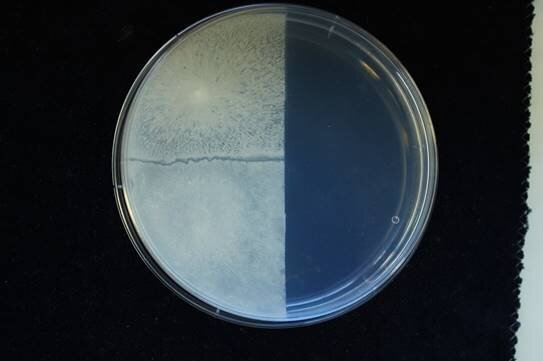

Microbial Interactions as a basis for bio-control of Campylobacter jejuni
Code: J4-2542 © included in ARRS records
Period 1.9. 2020- 30.8. 2023, Range 1,5 FTE
Head: Sonja Smole Možina
Abstract
Camyplobacteriosis is the most frequent food-borne bacterial intestinal infection in humans in developed countries resulting in high costs for the public health and economic sector (EFSA/ECDC, 2018).
In Slovenia, National Institute of Public Health recently reported 26% increase in prevalence of human campylobacteriosis in the period from 2015 to 2016 and 32% increase in comparison to 10-years average prevalence (NIJZ, 2017).
C. jejuni is a gastro-intestinal commensal of many animals, primarily avian. In the developed world, Campylobacter is usually acquired by consuming undercooked poultry meat.
In the EU, in spite of many efforts to solve this problem, the prevalence of Campylobacter positive chicken flocks may exceed 80% (EFSA/ECDC, 2018).
We will contribute to WPs in this project that address the interstrain interactions of C. jejuni genotypes in poultry from slaughtery, food contamination and human infection (Kovač et al., 2018).
In addition we will investigate the interspecies interactions of C. jejuni and B. subtilis in a variety of relevant conditions, including biofilms with the aim to decipher molecular mechanisms behind these interactions.

Development of Microflow Systems for Bacterial Cell Analysis, Selection and Application
Code: J4-1775 (C) - included in ARRS records
Period: 1.7.2019 - 30.06.2022 RANGE IN 2020: 1,45 FTE
Head: Žnidaršič Plazl Polona
Abstract
Development of microfluidic (MF) devices for biological applications enables a new approach for studying microorganisms which are usually cultivated in classical systems such as Petri dishes, shake-flasks and different types of bioreactors.
MF systems offer a unique, and physiologically more relevant environment for the cultivation of cells in controlled microenvironments and enable the detection of unstable metabolic intermediates, high throughput experimental procedures, in operando assessment of process parameters and the acquisition of kinetic parameter important for large-scale process design.
Continuous operation and low consumption of chemicals as well as integration with biosensors are another distinct advantage of MF systems.
With this proposal we wish to develop a MF system which will enable the study of physiology and metabolism of Bacillus subtilis, the model Gram-positive bacterium used for biofilm formation research as well as in industrial production of pharmaceuticals, vitamins, enzymes and food.
Furthermore B. subtilis endospores can be used for the development of cell-based biosensors that enable the detection of various organic compounds.
The project will encompass 5 work packages and WP1 will include the development of new strains using genetic engineering.
New recombinant strains will be developed to aid the study of growth, effect of micro-environmental conditions and other biotic factors in the MF system.
New strains will also be generated to achieve a deeper understanding of riboflavin metabolism and the suitability of using B. subtilis endospores as biosensors in the MF system.
In WP2 several MF system variations will be developed to enable the cultivation of B. subtilis in batch or continuous fashion, enable different approaches for oxygen delivery and several sensors will be tested and integrated.
In WP3 the MF system will be used to evaluate the cell response in different cultivation approaches (dispersed growth/biofilm), the effect of oxygen on metabolic activity will be evaluated and the impact on quorum sensing will be assessed.
In WP4 the MF system will be used for the evaluation of carbon, nitrogen and phosphorus on riboflavin metabolism and the results will be tested in a classical stirred tank bioreactor to enable system-to-system comparison.
In WP5 B. subtilis endospores will be immobilized in the MF system and tested as biosensors for the determination of antioxidant activity of various model compounds.
Significance for Science
Rapid development of microflow (MF) technology in recent years will be the starting point for the development of microflow bioreactors, which will enable unique highly controlled conditions for fundamental as well as applied studies on bacterial growth, metabolism and multicellularity. This project will demonstrate that phenomena as diverse as biofilm formation, riboflavin biosynthesis and biosensing in scientifically and industrially extremely relevant bacterium B. subtilis can be investigated with unprecedented throughput, precision and insight by using state-of-the-art microfluidics and cross-sectorial collaboration.

Horizon 2020
The H2020 widening ERA Chair
Chair Of Micro Process Engineering and Technology
COMPETE
Grant agreement ID: 811040, start day 2019
EU contribution: €2 500 000
Coordinator: Polona Žnidaršič Plazl
Objective
COMPETE is designed to capitalise on microfluidics research and technology, an existing knowledge base of University of Ljubljana (UL) to a leading European hub of microfluidics expertise.
Microfluidics offers huge potential for new solutions in biomedicine, biotechnology, food quality assessment and environmental protection, and is directly in line with the Slovenian Smart Specialization Strategy.
To achieve this ambition, the Chair will integrate micro-process engineering disciplines – chemical, mechanical and electrical engineering – with basic research in biophysics, chemistry and microbiology in order to overcome the main barriers for research excellence in this highly interdisciplinary field.
COMPETE will with help of the Chair holder address the lack of institutional organization connecting research teams, establish a wide network for collaborations that will improve the culture of research at UL and cooperation with other research, industrial, governmental and non-governmental entities.
Sustainability will be granted by research funding procurement for projects, structured cooperation with industrial and public research and educational entities, establishment of a new study field in the doctoral programs at UL, PhD summer school and other training programs. By setting a best practice example and through a well-thought outreach campaign the project aims to stimulate structural changes throughout UL.

Investigations of Cell-Cell Communications in Multi Cellular Groups Composed of Different Bacillus Isolates
Code: J4-9302 (C) - included in ARRS records
Period:1.7.2018 - 30.06.2021
Head: Mandić-Mulec Ines
Abstract
Microbe-microbe and plant –microbe interactions in the rhizosphere determine plant health, productivity and soil fertility. Plant growth-promoting bacteria (PGPR) are bacteria that can enhance plant growth and protect plants from disease and abiotic stresses through a wide variety of mechanisms.
These bacterial inoculants, especially endospore-forming Bacillus strains, have been proven as efficient and environmentally friendly alternatives to chemical pesticides and fertilizers. However, despite their many advantages, first generation PGPR often lack efficiency, failing to fulfil the expectations of the users, and new innovative approaches are needed to improve this eco-friendly technology.
This project will tackle this gap in understanding and provide answers that are of fundamental ecological importance by investigating bacterial 'social interactions'. Bacteria are perceived as 'social' in that they generally exist in multicellular groups of cells (biofilms) where they engage in a fierce and unforgiving competition for resources (food and space) but also in cooperative (synergistic) interactions that enhance productivity of the community.
The project will shed new light on two types of bacterial social interactions: a) Bacterial communication (also known as quorum sensing) and b) kin discrimination (KD). These behaviors will be studied in multicellular groups (biofilms) and also in relation to plant health.
Understanding how bacteria communicate, identify their social partners, synchronize their behaviors to conduct multicellular functions is of fundamental scientific importance and will be the focus of this project.
We predict that this knowledge is a key to improve PGPR inoculants and thus represents a highly innovative approach.
The strength of the project is that it combines ecologically and agriculturally relevant model bacteria (B. subtilis and related species), agriculturally relevant plants (e.g. potato, tomato), carefully designed and hypothesis-driven experiments and mathematical modelling, which are essential to predict behaviour of complex systems (e.g. bacterial biofilms/inoculants composed of more than two strains or species).
This novel strategy, based on understanding of QS and KD, will be addressed through joint efforts of three highly renowned research groups, from threee institutions: UL-BF, NIB and UM, that will generate fascinating discoveries important for development of new PGPR technologies based on fundamental understanding of Bacillus ecology and physiology.
The novelty, fundamental nature and broad importance of the proposed science guaranties that the findings will be published in highly respected journals, with potential for patent applications.
Significance for Science
The project is of fundamental importance as it will increase our understanding of cell-cell signalling mechanisms, kin discrimination and the impact and responses of genetically diverse bioinoculant communities. The approach is novel and hypothesis-driven and experiments will be designed based on ecological and evolutionary theory. The research has relevance to the wide range of signal-based and other interactive processes occurring in soil or on plant roots. The use of B. subtilis, a key, commercially important, environmentally friendly (GRAS), biocontrol agent provides additional relevance, because of its action against plant pathogens and growth promotion of economically important crops. Hypotheses that will be tested in this project are highly relevant for understanding of social evolution, understanding of fundamental biological principles of social interactions, mechanism of bacterial communications and plant response to microbial interactions. The state of the art comprises advanced methods in confocal microscopy, transcriptomic analyses and genetic engineering of bacterial strains together with mathematical modeling of social networks and will further advance these methodologies.
Global population increases and climate change pose a challenge to worldwide crop production and we are in urgent need of innovative solutions to combat abiotic stress, pathogens, and pests and PGPR represents a key solution to solve these challenges. Furthermore, Slovenia has limited agricultural lands and eco-friendly technologies and PGPR represent solution to preserve the productivity of our agricultural soils. The project will strengthen collaborations between three highly complementary Slovenian research groups in addition to international collaborations. Due to multidisciplinary approach the proposed scientific hypotheses will lead to important discoveries and high impact publications in the best journals, potentially also additional EU/international projects, in the medium-term, and in the long run provide opportunities for patenting and commercial exploitation.

The Role of Social and Genetic Kin Discrimination on B. Subtilis Interactions
Code: J4-8228 (D) - included in ARRS records
Period:1.5.2017 - 30.04.2020
Head: Štefanič Polonca
Abstract
Recently, we investigated soil bacterium, Bacillus subtilis for its ability to discriminate kin from non-kin strains in the context of swarming and for the first time identified kin groups of B. subtilis among natural isolates. Plant root co-colonization of kin strain pairs resulted in a mixed strain biofilm, whereas non-kin strains fought for the colonization of the plant root and eventually only one strain prevailed.
Problem description: The proposed project will focus on the study of ecological and evolutionary role of kin discrimination in the soil bacterium B. subtilis, which is unexplored. This microorganism is extremely important industrially and agriculturally. It is often used in formulations for support of agricultural plants against pathogens. New guidelines for the development of plant support inoculants are aimed at combining different bacterial strains. It is unknown whether antagonistic behaviour of non-kin B. subtilis strains on plant roots will affect the plant health or/and protect the plant from being attacked by pathogens?
The aim of the study: The project aims to determine the relationship between kin discrimination and territoriality, horizontal gene transfer, and ecosystem function. This knowledge will be then used to better understand biocontrol and plant growth promoting activity of B. subtilis.
We will test these activities on agricultural plants (tomato, tobacco, plants) and in the presence/absence of plant deadly pathogen (Ralstonia) using mixtures of kin and non-kin strains.
Comparative genomics on B. subtilis strains with a focus on how distribution of the antagonistic loci correlates with the phylogenetic distance, kin and pherotype groups will be performed.
Originality of the results: B. subtilis is a soil organism with promising biocontrol activities. To this date it is unknown how antagonistic interactions between strains influence the plants. Given that antagonistic interactions between non-kin B. subtilis include the secretion of antimicrobial compounds these may protect the plant from pathogen invasion.
Also, B. subtilis can protect the plant by competing for the plant root colonization area. These questions have never been addressed before in the context of kin discrimination and the results will give us valuable information about inter-species interactions that could potentially lead to a more efficient microbial biocontrol development and to commercialization of this research.
Methods: Our laboratories have environmental Bacillus strains from two collections, namely soil and rhizosphere.
Significance for Science
The project is based on the exceptional recent discovery of kin discrimination and years of research in the field of ecology and social interactions of Bacillus subtilis, which has for decades been an excellent model organism for basic research in biofilms, horizontal gene transfer, swarming, sporulation, and is of broad interest for many research groups and industry around the world. Furthermore, this soil and plant-root associated bacterium B. subtilis is useful for the health of the plants. The proposed research is linked to the interaction of B. subtilis with plants and the plant pathogen Ralstonia solanacearum. The projects combines ecological and molecular approaches to test five interesting scientific hypotheses that address the evolutionary importance of kin discrimination, its influence on horizontal gene transfer and bacterial territoriality and combines this knowledge with application of these bacteria in plant support. The hypotheses are of fundamental importance and have not yet been confirmed in the context of bacterial kin discrimination.

Investigations of Bacterial Social Interactions in Biotechnologically and Medically Important Microbial Biofilms
Code: J4-7637 (D) - included in ARRS records
Period:1.3.2016 - 28.02.2019 RANGE:1,5 FTE; 0,8 FTE for the MM lab
Head: Mandić-Mulec Ines
Abstract
Scientific background: Bacteria have evolved over billions of years to engage in multicellular networks dominated by complex social interactions. Although bacteria have the ability to live an independent solitary lifestyle they continuously adapt to the presence of other microorganisms.
In fact, it is believed that 17 – 42 % of predicted ORFs in published genomes are dedicated to microbial interactions (Phelan et al., 2012), which are mediated by secreted molecules (public goods) such as signals, surfactants, antibiotics, toxins, extracellular polymers, extracellular enzymes. These influence the fitness and physiology of the producer as well as of neighbouring bacteria (Oslizlo et al., 2014).
Social interactions are especially intense in biofilms where cells live in close proximity and are glued together by a complex network of extracellular polymers (Dogša et al., 2014). For example, Bacillus and Actinomyces species, both soil dwelling and industrially important Gram-positive bacteria, may mutually influence the production of each other’s secretions in biofilms (Traxler and Kolter, 2015). Actinomycetes are known antibiotic producers and the genomes of Streptomyces encode numerousl secondary metabolite gene clusters of unknown function (Baranasic et al., 2013).
In addition Bacillus my interact with pathogenic bacteria such as Campylobacter jejuni, the leading causes of human gastroenteritis worldwide (Smole Možina et al., 2011) yet the molecular mechanisms of these interactions are poorly understood.
Aims: The project aims to investigate basic mechanisms of intra and interspecies social interactions that affect development of mixed biofilms, fitness of interacting bacteria, synthesis of antibiotics and matrix polymers, stress response, and mechanical properties of biofilms.
Significance for Science
Social microbiology is an emerging and dynamic field of research that is changing our perceptions of the microbial world and we believe that the results of this project will further boost our understanding of microbial social interactions including the effect of sociality on mechanical properties of mixed species biofilms, the distribution of cell clusters in these multicellular structures and secretions that are induced by interactions.
Metagenomics for Bioexploration and Biomining of Bacterial Laccases for a Sustainable Environment
Code: J4-4250 (D) - included in ARRS records
Period: 1.7.2011 - 30.06.2014 RANGE IN 2014: 0, 6 FTE
Head: Mandić-Mulec Ines
Abstract
Microorganisms comprise the largest resource of metabolic and genetic diversity on Earth. This vast diversity can be explored to better understand links between diversity and ecosystem function and for biotechnological innovation.
One important example is a group of environmentally important microbial enzymes, laccases, which are already used in various biotechnological applications (see below). Laccases (benzenediol: oxygen oxidoreductases) are blue multi-copper enzymes with broad substrate specificity towards aromatic compounds and participate in cross-linking of monomers, degradation of polymers and ring cleavage of aromatic compounds.
These enzymes oxidise a wide range of important polyphenolic substances in the presence of oxygen, including lignin, antimicrobial agents, and compounds used in personal care products (PCPs) and pharmaceuticals.
Microorganisms provide a rich and diverse source of laccases but most microorganisms in natural ecosystems (more than 99.9%) are not cultivable and many interesting targets are accessible only via metagenomics-based tools.
Metagenomics allows the cultivation-independent discovery of both the function and diversity of microbial consortia in their natural habitats and is a new and powerful tool for bio-exploration and bio-mining of novel enzymatic functions for sustainable environments.
Problem description: Fungal laccases, that have been studied most, are already used for many industrial applications in the paper, textile, pharmaceutical and petrochemical industries, and have been targeted to improve total hydrolysis of lignocellulosic biomass for energy and chemical production and for bio detection and elimination of environmental pollution.
These enzymes are also present in prokaryotes, and bacterial laccases are, importantly, much more robust (tolerant to high pH, temperature) than fungal laccases.
We recently developed new tools to detect bacterial laccases and discovered a vast diversity of bacterial laccase genes in peat soils of the Ljubljana marsh (Ausec et al, 2011) and in collaboration with the Buidefeld University developed hidden Markov models to search for two- and three-domain bacterial laccases in bacterial genomes in public databases and identified 1,200 novel putative laccase genes (Ausec et al.2011).
The aim of the study: The aim of this study was to discover novel bacterial laccase genes with robust properties (e.g. high pH optimum) for potential commercial application in industry, environmental biotechnology and as biosensors for environmental pollutants.
Significance for Science
Laccase are oxidoreductase that are highly versatile enzymes and of high interest for many industrial and environmental applications including paper and textile industry, pharmaceutical or food industry but are also of high interest as enzymes added to increase efficiency of biofuel production or removal of toxic chemicals from the environment.
The results gained within this project were published in several eminent journals and have brought invitations to present results at foreign universities and international conferences including an invited lecture at the most important EU conference in Europe (FEMS) as well as the request to organize and chair the section on soil metagenomics. The latter is the prime subject of this project which has strongly benefited from collaborations with members of the METAEXPLORE FP 7 projects.

Ecology of Social Interactions in Bacillus subtilis
Code: J4-3631 (D) - included in ARRS records
Period: 1.5.2010 - 30.04.2013
Head: Mandić-Mulec Ines
Abstract
Bacteria use cell-cell signaling (social interactions) to control important cellular processes (e.g. synthesis of antibiotics, biofilm formation) in response to cell density.
Signaling is mediated by small molecules, which accumulate in the extracellular environment. Upon reaching a critical concentration signaling molecules induce gene expression, resulting in coordinated adaptive responses of the population. In a Gram positive bacterium Bacillus subtilis, the ComQXPA communication system controls production of a lipopeptide antibiotic surfactin and many other adaptive processes.
The first three genes of the communication locus are highly polymorphic, leading to the formation of four different communication groups. Communication is possible between strains within the same group, but not between strains belonging to different groups (Štefanič et al, 2009).
The aim of the study was to determine the relationship between environment (soil or rhizosphere), microbial diversity (B. subtilis communication groups or pherotypes), social interactions (cell signaling), ecotypes and ecosystem function (plant biocontrol).
The project has provided novel insight into the diversity of ecotypes and pherotypes (signaling specificity groups)(Štefanič et al., 2012) and revealed that tomato plants are colonized with B. subtilis strains of different communication types (Oslizlo et al., 2015).
Significance for Science
Bacterial intercellular signaling is essential for coordination of survival strategies at the population level and understanding of this process is important for optimization of procedures applying bacteria as production organisms in industry, as probiotics for human health and husbandry or as biopesticides in agriculture.
The project ‘Ecology of social interactions of Bacillus subtilis aimed to understand bacterial communication by focusing on the ComQXPA quorum sensing (QS) system. This QS system is especially interesting due to its high polymorphism, which increases the specificity of the response and prevents communication between strains of different communication types (pherotypes).
Using in vitro and in situ models, we showed that pherotypes strongly correlate with ecotypes broadening our understanding of evolutionary forces contributing to diversification of pherotypes (Štefanič et al., Env. Microbiol., 2012). In addition we provided through a bioinformatics analysis a novel insight into the distribution of ComQXPA QS systems in sequenced bacterial genomes (Dogša et al ., PloS one 2014) as well as we have shown that strains with diverse communication loci colonize one tomato plant (Oslizlo et a, Environmental. Microbiol reports, 2015). We believe that this will encourage research of ComQXPA QS systems in other bacterial species.